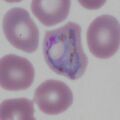

Uncategorized files
Showing below up to 50 results in range #151 to #200.
-
Mp4.jpg 472 × 472; 64 KB
-
New Malaria Lifecycle.jpg 709 × 840; 211 KB
-
PFET-synchronous.jpg 472 × 472; 42 KB
-
PFET1g.jpg 472 × 472; 52 KB
-
PFET2g.jpg 472 × 472; 51 KB
-
PFET3g.jpg 472 × 472; 76 KB
-
PFET3mag.jpg 472 × 472; 79 KB
-
PFET4g.jpg 472 × 472; 80 KB
-
PFETanno.jpg 472 × 472; 213 KB
-
PFETc.jpg 472 × 472; 197 KB
-
PFETinfo.jpg 472 × 472; 201 KB
-
PFG1.jpg 472 × 472; 36 KB
-
PFG1mag.jpg 472 × 472; 40 KB
-
PFG2.jpg 472 × 472; 41 KB
-
PFG3.jpg 472 × 472; 31 KB
-
PFG4.jpg 472 × 472; 44 KB
-
PFGanno.jpg 472 × 472; 71 KB
-
PFGc.jpg 472 × 472; 48 KB
-
PFGinfo.jpg 472 × 472; 53 KB
-
PFLT1p.jpg 472 × 472; 48 KB
-
PFLT2p.jpg 472 × 472; 48 KB
-
PFLT3p.jpg 472 × 472; 51 KB
-
PFLT4p.jpg 472 × 472; 49 KB
-
PFLTanno.jpg 472 × 472; 62 KB
-
PFLTc.jpg 472 × 472; 41 KB
-
PFLTinfo.jpg 472 × 472; 44 KB
-
PFS1p.jpg 472 × 472; 27 KB
-
PFS2p.jpg 472 × 472; 56 KB
-
PFS3p.jpg 472 × 472; 40 KB
-
PFS4p.jpg 472 × 472; 38 KB
-
PFSanno.jpg 472 × 472; 68 KB
-
PFSc.jpg 472 × 472; 45 KB
-
PFSinfo.jpg 472 × 472; 49 KB
-
PFcentral.jpg 472 × 472; 30 KB
-
PHcorrect.jpg 472 × 472; 68 KB
-
PHincorrect.jpg 472 × 472; 76 KB
-
PHincorrect2.jpg 472 × 472; 97 KB
-
PKBand.jpg 472 × 472; 26 KB
-
PKET1a.jpg 472 × 472; 32 KB
-
PKET2a.jpg 472 × 472; 31 KB
-
PKET3a.jpg 472 × 472; 33 KB
-
PKET4a.jpg 472 × 472; 33 KB
-
PKETanno.jpg 472 × 472; 65 KB
-
PKETc.jpg 472 × 472; 41 KB
-
PKG1.jpg 472 × 472; 28 KB
-
PKG2.jpg 472 × 472; 34 KB
-
PKGanno.jpg 472 × 472; 69 KB
-
PKGc.jpg 177 × 177; 26 KB
-
PKLT1.jpg 472 × 472; 36 KB
-
PKLT2.jpg 300 × 300; 17 KB